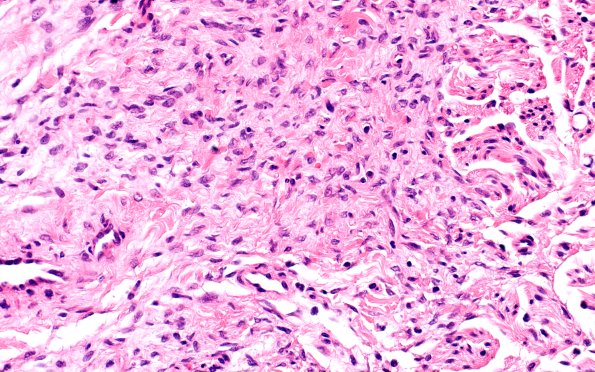
25F4 Nerve Trauma (Case 25) H&E 40X

Table of Contents
Washington University Experience | PERIPHERAL NEUROPATHY | 19 TRAUMATIC INJURIES | 25F4 Nerve Trauma (Case 25) H&E 40X
Some areas of haphazard growth and relatively few mini-fascicles are seen at this level. (H&E). Within the nerve fascicles, there is a haphazard proliferation of neurites, Schwann cells, and fibroblasts separated by areas of fibrosis. (H&E)